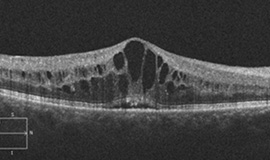
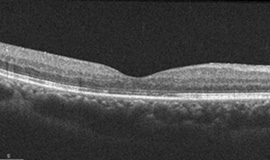

당뇨망막병증이란?
당뇨망막병증은 당뇨로 인해 망막의 미세혈관이 손상되어 발생하는 가장 흔한 미세혈관 합병증입니다.
망막에 출혈과 부종, 신생혈관이 생기면서 시력이 빠르게 악화되고, 결국 실명에 이르게 됩니다.


당뇨망막병증
정상안
발생 원인과
위험 요인
- 당뇨병의 유병 기간이 길수록 발병 위험이 높아집니다.
예컨대, 당뇨병을 15년 이상 앓으면 약 절반 정도에서 망막병증이 나타날 수 있습니다. - 고혈당, 고혈압, 고지혈증, 흡연, 신장 질환 등이 진행을 촉진시킵니다.
- 혈당 조절이 불안정한 경우 특히 빠른 악화를 보일 수 있습니다.
진행 단계와
주요 증상
1. 비증식당뇨망막병증
- 망막혈관이 막히거나 손상되어 망막출혈, 삼출물, 망막부종을 유발합니다.
- 초기에는 증상이 없는 경우가 대부분이어서 정기 검진이 필수적입니다.
2. 증식당뇨망막병증
- 망막에 비정상적인 신생혈관이 자라 출혈과 망막박리를 유발할 수 있으며, 심한 시력 저하나 실명의 원인이 됩니다.


3. 대표 증상
- 시야 흐림, 비문증(날파리 증상), 중심암점, 야간 시력 저하 등.
- 그러나 증상이 늦게 나타나므로 조기 진단을 위한 정기 검진이 매우 중요합니다.
진단 방법
산동 후 정밀 안저검사
형광안저혈관조영술
빛간섭단단층촬영(OCT)
시야검사
당뇨망막병증 진단 방법
검사를 통해 망막 상태를 정확하게 평가하고 치료 계획을 수립합니다.
치료 방법
1. 혈당 및 전신질환 관리
- 가장 기본적이고 중요한 치료
2. 레이저광응고술
 증식당뇨망막병증에서범망막레이저광응고술
증식당뇨망막병증에서범망막레이저광응고술- 신생혈관의 성장을 억제하고, 출혈과 망막박리의 위험을 줄임.
3. 유리체내 주사
- 당뇨황반부종의 표준 치료로서 망막부종을 줄이고 시력을 보존하는데 효과적임.
당뇨황반부종에 대한 유리체내 주사 전
당뇨황반부종에 대한 유리체내 주사 전 당뇨황반부종에 대한 유리체내 주사 후
당뇨황반부종에 대한 유리체내 주사 후4. 유리체절제술
- 심한 유리체출혈이나 망막박리 등이 발생한 경우 수술적 치료가 필요함.
 증식당뇨망막병증에서
증식당뇨망막병증에서 유리체절제술
 섬유혈관증식과 견인망막박리
섬유혈관증식과 견인망막박리 유리체절제술 후
유리체절제술 후 양안
양안 고위험증식당뇨망막병증 ①
 유리체절제술 후 ①
유리체절제술 후 ① 양안
양안 고위험증식당뇨망막병증 ②
 유리체절제술 후 ②
유리체절제술 후 ②예후와 관리
- 치료 후에도 정기적인 경과관찰이 반드시 필요합니다.
- 조기 발견 시 시력 보존 가능성이 크지만, 진행 후 발견하면 치료 효과가 제한적입니다.
- 정기적인 눈 검진을 통한 관리가 시력 보호의 핵심입니다.
왜 모두다연세안과일까?
01
대학병원급 첨단 장비로
정확한 진단
02
다양한 유리체내 주사 및
최신 망막
레이저치료 시스템 구축
03
당뇨 내과와의 긴밀한 협진
네트워크를 통해
환자 맞춤형 치료 및 장기 관리
모두다연세안과의 배정훈 원장은 다년간 고위험 당뇨망막병증 환자를 치료해온 풍부한 경험을 바탕으로
당뇨병 환자들께서 신뢰할 수 있는 진료를 약속 드립니다.










